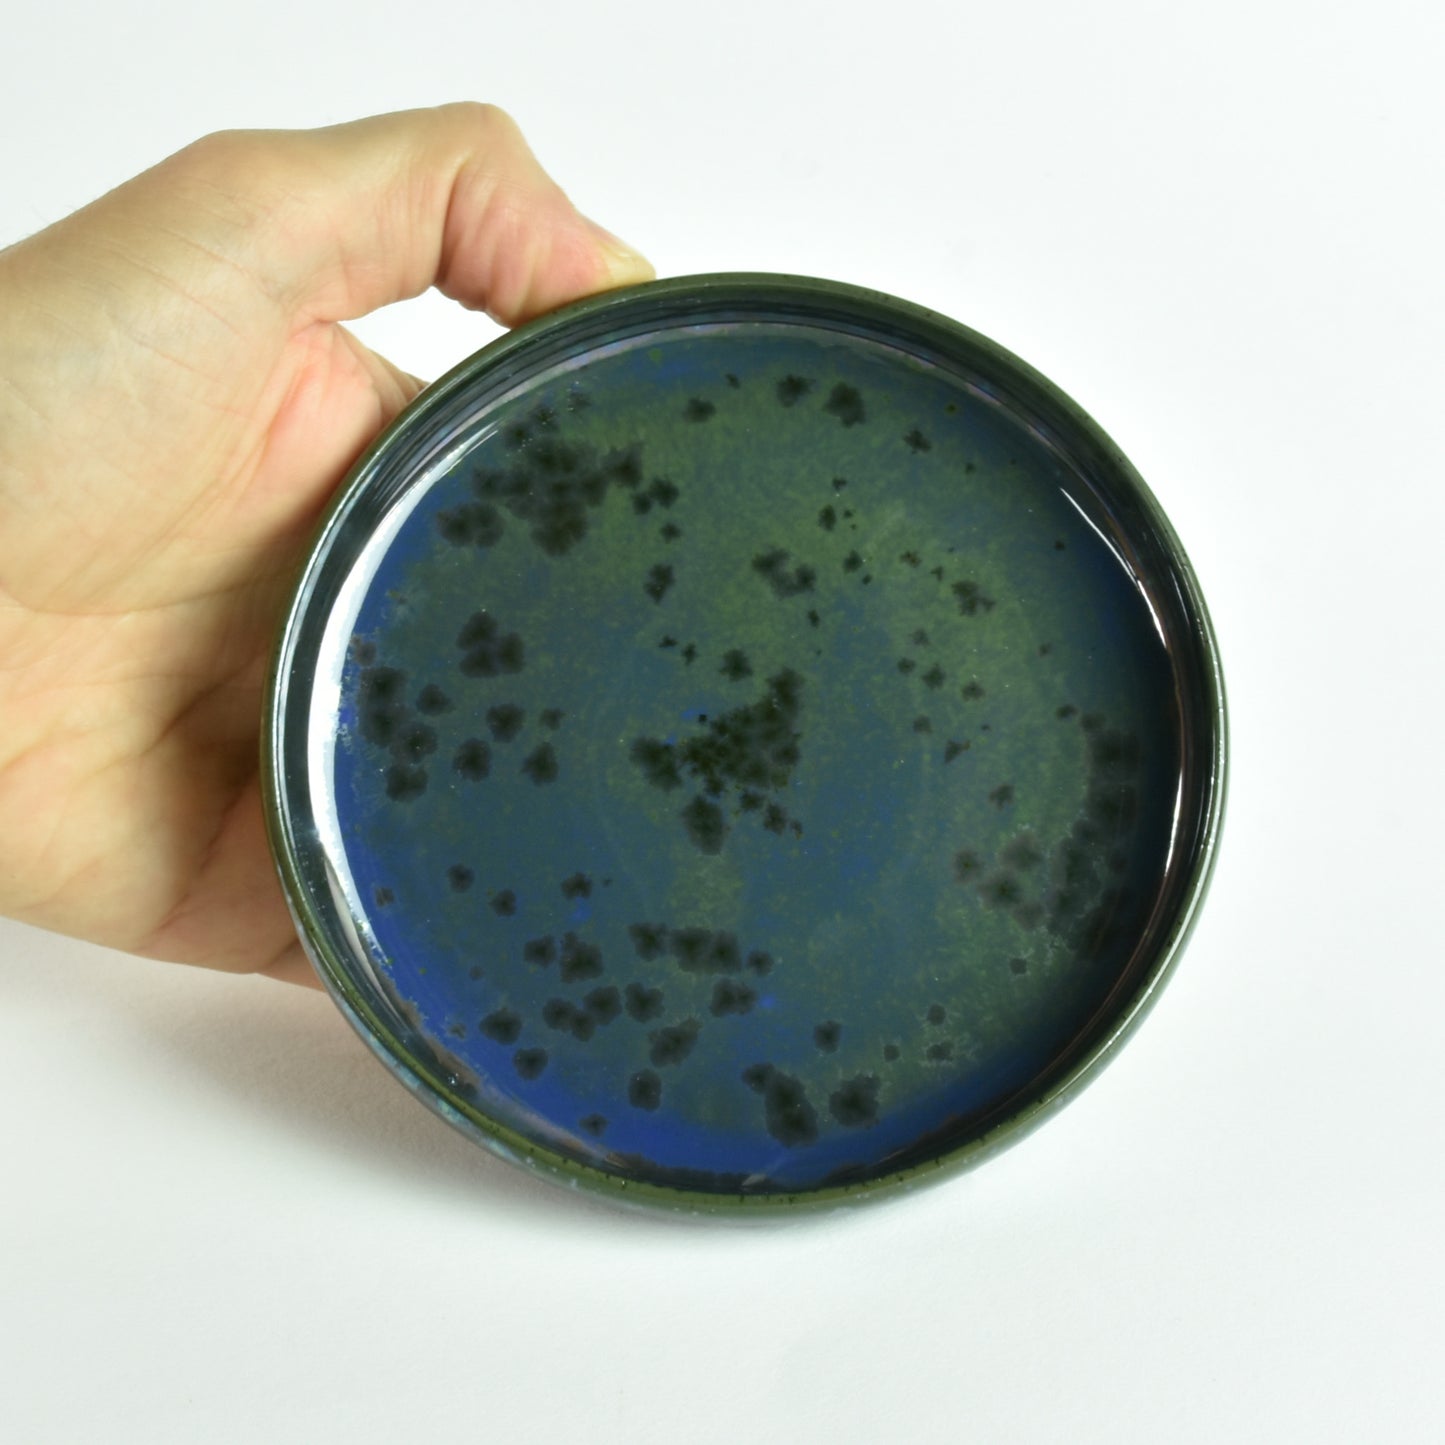

wafflepottery
Pin Dish "Lapis Lazuli"
- Regular price
- $83.00 AUD
- Regular price
-
- Sale price
- $83.00 AUD
- Unit price
- per
Couldn't load pickup availability
This beautiful wheel-thrown pottery dish will sit by your side while you sew, keeping your pins safely stored and accessible.
Each pin dish includes a strong magnet to keep your pins securely in place.
The pin dish you choose will look like the product image, but not be exactly the same due to the handmade nature of this item.
Aside from clay and glazes, these also include: rare earth magnet (neodymium magnet), epoxy resin and ethically sourced cork for the base.
This Pin Dish has a twin: Lapis Lazuli Thread Bin 💡
Important Information:
**Neodymium (Rare Earth) Magnets are more powerful than standard Ferrite magnets and should be handled with caution.
Keep out of reach of children.
People with pacemakers should avoid handling magnets.
Magnets may cause permanent damage to personal items such as credit cards, computer hard drives, watches, TVs, data storage, and other electronic devices and objets (like computerised sewing machines) so please take care to use this pin dish on a desk or solid surface, and do not place on your sewing machine.
This dish is intended for storing pins only. It is not to be used for serving food as the glaze may not have been tested for food safety.
Share